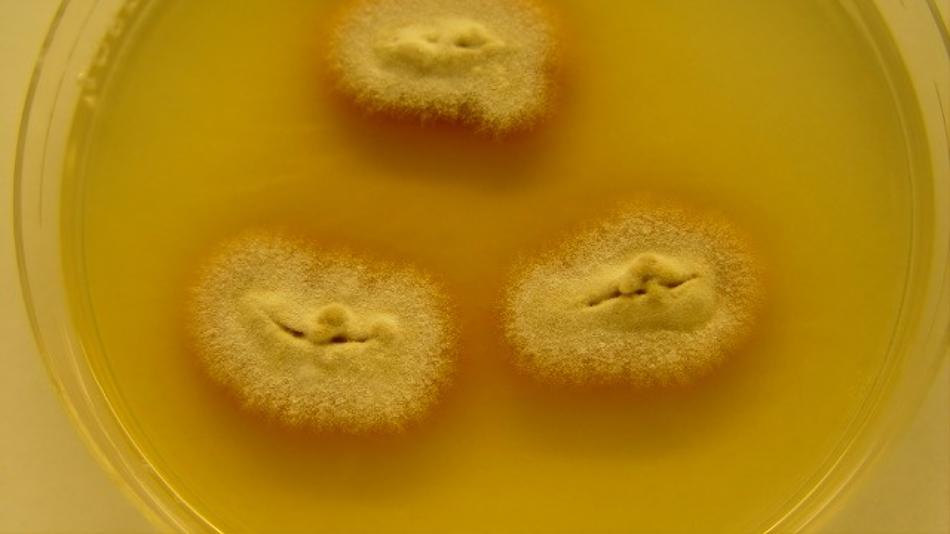
Mikroskopielabor

Mitmachstation
Die Welt der Infektionskrankheiten
Durchschnittliche Verweildauer: 20 Minuten
Entdecke die Welt der Infektionskrankheiten – spannend und verständlich erklärt! Bei uns dreht sich alles um Krankheiten, die durch Bakterien und Pilze verursacht werden. In kurzen, leicht verständlichen Vorträgen erfährst du, wie sich diese Erreger verbreiten, wie sie unseren Körper krank machen und was man dagegen tun kann. Ein besonderes Highlight: Die Erreger werden nicht nur erklärt, sondern auch gezeigt! Du kannst echte Kulturen und mikroskopische Präparate anschauen und sehen, wie winzig – aber wirkungsvoll – diese Krankheitserreger sind.
Als Beispiele sprechen wir über vermehrt auftretende Pilzinfektionen durch Trichophyton tonsurans, einen Hautpilz, der vor allem Haare und Kopfhaut befällt. Außerdem erklären wir, was eine Sepsis (Blutvergiftung) ist – eine gefährliche Reaktion des Körpers auf Infektionen – und warum schnelles Handeln hier lebenswichtig ist.
Zusätzlich zeigen wir, was ein Antibiogramm ist und wie es hilft, das richtige Antibiotikum für die Behandlung auszuwählen.
Vorkenntnisse sind nicht nötig – Neugier genügt!
Besucherinformation
Anfahrtsbeschreibung: Die näheste U Bahn Station ist U6, Michelbeuern AKH Nächste LNF Stationen: Zentrum für Translationale Medizin - 1 Min Hochfeld MR Zentrum - 2 Min Mitmachlabor Mikroskopie - 2 Min Hörsaalzentrum - 3 Min Ignaz Semmelweis Statue - 4 Min Sigmund Freud Statue - 4 Min Alles Notfall - 5 Min
Dieser Ausstellungsstandort ist barrierefrei zugänglich.
Öffnungszeiten
6 weitere Stationen an diesem Standort
-
 AusstellungErkundung des UnsichtbarenThema: GesundheitBesucher:innen können anhand einer fixierten Zellplatte Zellschäden, die durch das Masernvirus verursacht werden, unter dem Mikroskop betrachten. Zusätzlich lädt eine interaktive Tafel dazu ein, verschiedene Viren ihren typischen klinischen Symptomen zuzuordnen.Medizinische Forschungsmeile17:00 - 23:00
AusstellungErkundung des UnsichtbarenThema: GesundheitBesucher:innen können anhand einer fixierten Zellplatte Zellschäden, die durch das Masernvirus verursacht werden, unter dem Mikroskop betrachten. Zusätzlich lädt eine interaktive Tafel dazu ein, verschiedene Viren ihren typischen klinischen Symptomen zuzuordnen.Medizinische Forschungsmeile17:00 - 23:00 -
 MitmachstationHighway2Cell - Zellen und Moleküle zum Greifen nah: 1. Wie schauen sich Forscher:innen Zellen an?Thema: Digitalisierung GesundheitIn dieser Station werden wir mit modernsten Geräten aufgenommene Mikroskopie-Bilder von Geweben vorstellen und verglichen. So finden Forscher:innen etwa Krebszellen oder Entzündungen im Körper.Medizinische Forschungsmeile17:00 - 23:00
MitmachstationHighway2Cell - Zellen und Moleküle zum Greifen nah: 1. Wie schauen sich Forscher:innen Zellen an?Thema: Digitalisierung GesundheitIn dieser Station werden wir mit modernsten Geräten aufgenommene Mikroskopie-Bilder von Geweben vorstellen und verglichen. So finden Forscher:innen etwa Krebszellen oder Entzündungen im Körper.Medizinische Forschungsmeile17:00 - 23:00 -
 MitmachstationHighway2Cell - Zellen und Moleküle zum Greifen nah: 2. Wie werden Zellen sortiert (und warum)?Thema: Digitalisierung GesundheitIn dieser Station werden wir ein Zellsortierungsexperiment simulieren, wie es z.B. zur Bestimmung der zellulären Zusammensetzung von Blutproben im Labor durchgeführt wird. Unsere Leukozyten und Granulozyten werden in diesem Experiment durch essbare "Zellen" ersetzt.Medizinische Forschungsmeile17:00 - 23:00
MitmachstationHighway2Cell - Zellen und Moleküle zum Greifen nah: 2. Wie werden Zellen sortiert (und warum)?Thema: Digitalisierung GesundheitIn dieser Station werden wir ein Zellsortierungsexperiment simulieren, wie es z.B. zur Bestimmung der zellulären Zusammensetzung von Blutproben im Labor durchgeführt wird. Unsere Leukozyten und Granulozyten werden in diesem Experiment durch essbare "Zellen" ersetzt.Medizinische Forschungsmeile17:00 - 23:00 -
 MitmachstationHighway2Cell - Zellen und Moleküle zum Greifen nah: 3. Was sind Gene und wie lesen wir sie?Thema: Digitalisierung GesundheitIn dieser Station werden wir Gene sequenzieren und unsere Lieblingsgene auffädeln zum mit nach Hause nehmen.Medizinische Forschungsmeile17:00 - 23:00
MitmachstationHighway2Cell - Zellen und Moleküle zum Greifen nah: 3. Was sind Gene und wie lesen wir sie?Thema: Digitalisierung GesundheitIn dieser Station werden wir Gene sequenzieren und unsere Lieblingsgene auffädeln zum mit nach Hause nehmen.Medizinische Forschungsmeile17:00 - 23:00 -
 MitmachstationHighway2Cell - Zellen und Moleküle zum Greifen nah: 4. Und wann kommt hier der Computer ins Spiel?Thema: Digitalisierung GesundheitIn diesem Experiment simulieren wir ein großes Datenset mit Hilfe einer Sammlung von bunten, kleinen Gegenständen und schauen uns an, wie dieses unter Anwendung der Methode "Dimensionalitätsreduktion" analysieren können.Medizinische Forschungsmeile17:00 - 23:00
MitmachstationHighway2Cell - Zellen und Moleküle zum Greifen nah: 4. Und wann kommt hier der Computer ins Spiel?Thema: Digitalisierung GesundheitIn diesem Experiment simulieren wir ein großes Datenset mit Hilfe einer Sammlung von bunten, kleinen Gegenständen und schauen uns an, wie dieses unter Anwendung der Methode "Dimensionalitätsreduktion" analysieren können.Medizinische Forschungsmeile17:00 - 23:00 -
 MitmachstationWas sticht mich denn da? - Einblick in die Welt der medizinisch relevanten Insekten und Zecken in ÖsterreichThema: Naturwissenschaften UmweltDie Station “Was sticht mich denn da? - Einblick in die Welt der medizinisch relevanten Insekten und Zecken in Österreich” gibt Besucher:innen einen Überblick über die medizinisch relevante Arthropoden-Fauna (Insekten und Zecken) in Österreich.Medizinische Forschungsmeile17:00 - 23:00
MitmachstationWas sticht mich denn da? - Einblick in die Welt der medizinisch relevanten Insekten und Zecken in ÖsterreichThema: Naturwissenschaften UmweltDie Station “Was sticht mich denn da? - Einblick in die Welt der medizinisch relevanten Insekten und Zecken in Österreich” gibt Besucher:innen einen Überblick über die medizinisch relevante Arthropoden-Fauna (Insekten und Zecken) in Österreich.Medizinische Forschungsmeile17:00 - 23:00






